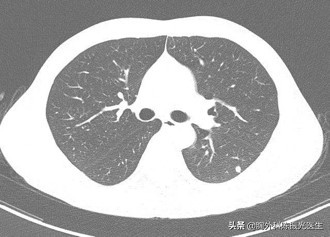
不同类型肺癌的化疗方案,不同类型的肺癌症状区别

不同患者有不同的肺癌分期,不同的肺癌分期又有不同的治疗策略,说起来很复杂,其实都在下面这个图里面,要弄个大概明白也不难。

早期患者,也就是IA、IB期肺癌患者
积极手术切除(可以选择解剖性肺叶切除+肺门纵隔淋巴结清扫术,或者微创技术下的解剖性肺叶切除+肺门纵隔淋巴结清扫术);如果心肺功能差无法手术,或者死活不愿意手术,可以选择立体定向放疗。
手术后IA期不建议再使用抗癌药物治疗,IB期可以选择使用也可以不用抗癌药物治疗,抗癌药物根据基因检测结果选择靶向药物还是化疗。
中期患者,也就是IIA、IIB期肺癌
积极手术切除(可以选择解剖性肺叶切除+肺门纵隔淋巴结清扫术,或者微创技术下的解剖性肺叶切除+肺门纵隔淋巴结清扫术),手术后必须使用抗癌药物预防复发转移,根据基因检测结果选择靶向药物还是化疗。
如果心肺功能差无法手术,或者死活不愿意手术,可以根据基因结果选择使用靶向药物和化疗,再结合放射治疗。
IIIA期肺癌可能有两种情况
第一种情况
患者是可能可以手术的,有下列情况,考虑先做手术前诱导治疗后再手术。
1、肺上沟瘤; 2、同一肺叶内转移; 3、单个纵隔淋巴结非巨块型转移预期可完全切除; 4、多个纵隔淋巴结转移但预期可能完全切除。
术前诱导治疗,又称为“术前新辅助治疗”。包括化疗后手术、靶向药物治疗后手术,术后要继续使用抗癌药物治疗,可以根据基因结果选择使用靶向治疗和化疗。
第二种情况
IIIA期肺癌的另一种情况,包括(同侧纵隔淋巴结多枚转移成巨大肿块、对侧肺门纵隔淋巴结或锁骨上淋巴结转移、病灶侵犯心脏、主动脉和食管)。
和IIIB期一样,属于中晚期,不可能手术了,根据基因结果选择使用靶向药物和化疗等抗癌药物治疗,可以联合放疗。
IV期肺癌,也就是晚期肺癌
根据基因选择靶向药治疗。
(1)如EGFR基因阳性
选用第一代EGFR靶向药(易瑞沙、特罗凯、凯美纳)、第二代药物阿法替尼、第三代药物泰瑞沙;
(2)ALK基因阳性
选用第一代ALK靶向药克唑替尼、第二代ALK靶向药(色瑞替尼、艾乐替尼);
(3)BRAFV600E基因突变
选用达拉菲尼、曲美替尼;
(4)ROS1基因重排
选用色瑞替尼、克唑替尼。
如果没有基因突变则要使用化疗治疗,身体条件太差的只能采用营养支持治疗。
有点复杂,你明白了吗?
写在最后
如果有肺结节或肺癌问题向我咨询,可以关注头条并私信留言,我将和你联系,对于我能帮助的朋友,我会通过视频或见面与你沟通。
#清风计划# #春季养生正当时# #我的门诊故事#